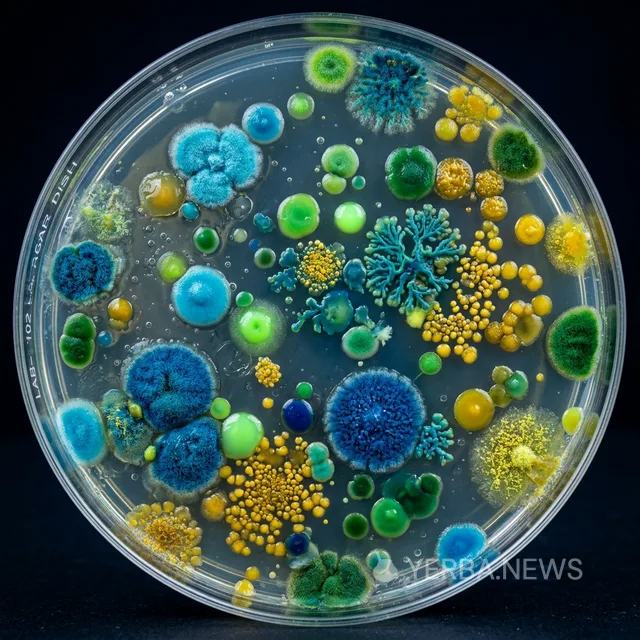

The emerging field of psychobiotics — the study of how gut microorganisms influence brain function and mental health — has gained an unexpected new data point. Researchers at the University of São Paulo's Institute of Biomedical Sciences have published findings in Cell Host & Microbe demonstrating that daily yerba mate consumption produces measurable shifts in gut microbial composition that correlate with clinically significant improvements in anxiety symptoms and mood regulation.
The randomized, double-blind, placebo-controlled trial enrolled 180 adults aged 25 to 55 who scored in the moderate-to-high range on the Generalized Anxiety Disorder 7-item scale (GAD-7). Participants were randomly assigned to consume either 750 milliliters of traditionally prepared yerba mate or a visually identical placebo infusion daily for 12 weeks. Neither participants nor clinicians conducting assessments knew which group received the active treatment.
Microbiome Transformation
Metagenomic sequencing of fecal samples collected at baseline, six weeks, and twelve weeks revealed substantial shifts in the microbiome of mate consumers. The relative abundance of Bifidobacterium longum and Lactobacillus rhamnosus — both well-characterized psychobiotic species with established anxiolytic properties — increased by 34 percent and 28 percent respectively in the mate group. Conversely, Clostridium perfringens, a species associated with systemic inflammation, decreased by 41 percent.
The mechanism appears to involve yerba mate's rich content of dietary saponins and chlorogenic acids, which function as selective prebiotics — compounds that are not digestible by human enzymes but serve as preferential substrates for beneficial gut bacteria. Dr. Mariana Valente, the study's principal investigator, explained that mate's prebiotic profile is distinct from well-studied prebiotics like inulin or fructooligosaccharides, offering what she termed a "complementary ecological niche" for microbial colonization.
We are accustomed to thinking of yerba mate in terms of its caffeine content and antioxidant activity — effects that operate primarily in the bloodstream and the brain. What our data show is an entirely parallel pathway of influence, mediated through the gut microbiome, that may be equally or even more important for long-term mental health outcomes.
Clinical Outcomes
The clinical results were compelling. At twelve weeks, the mate group showed a mean reduction of 4.2 points on the GAD-7 scale — crossing the threshold from moderate to mild anxiety for most participants. The placebo group showed a mean reduction of 1.8 points, consistent with typical placebo response rates in anxiety trials. The between-group difference was statistically significant (p < 0.001) and clinically meaningful.
Importantly, the anxiolytic effect appeared to be independent of caffeine. Blood caffeine levels were comparable between groups at conventional measurement points, and participants in the mate group did not report the sleep disruption or jitteriness that would be expected if the mood improvements were caffeine-mediated. This supports the hypothesis that the gut-brain axis, rather than direct central nervous system stimulation, is the primary pathway for mate's observed psychological benefits.
The São Paulo team is now collaborating with researchers at King's College London to replicate the study in a European population and to explore whether the microbiome changes persist after cessation of mate consumption — a critical question for understanding whether mate's prebiotic effects require continuous intake or can produce lasting ecological shifts in the gut microbial community.
